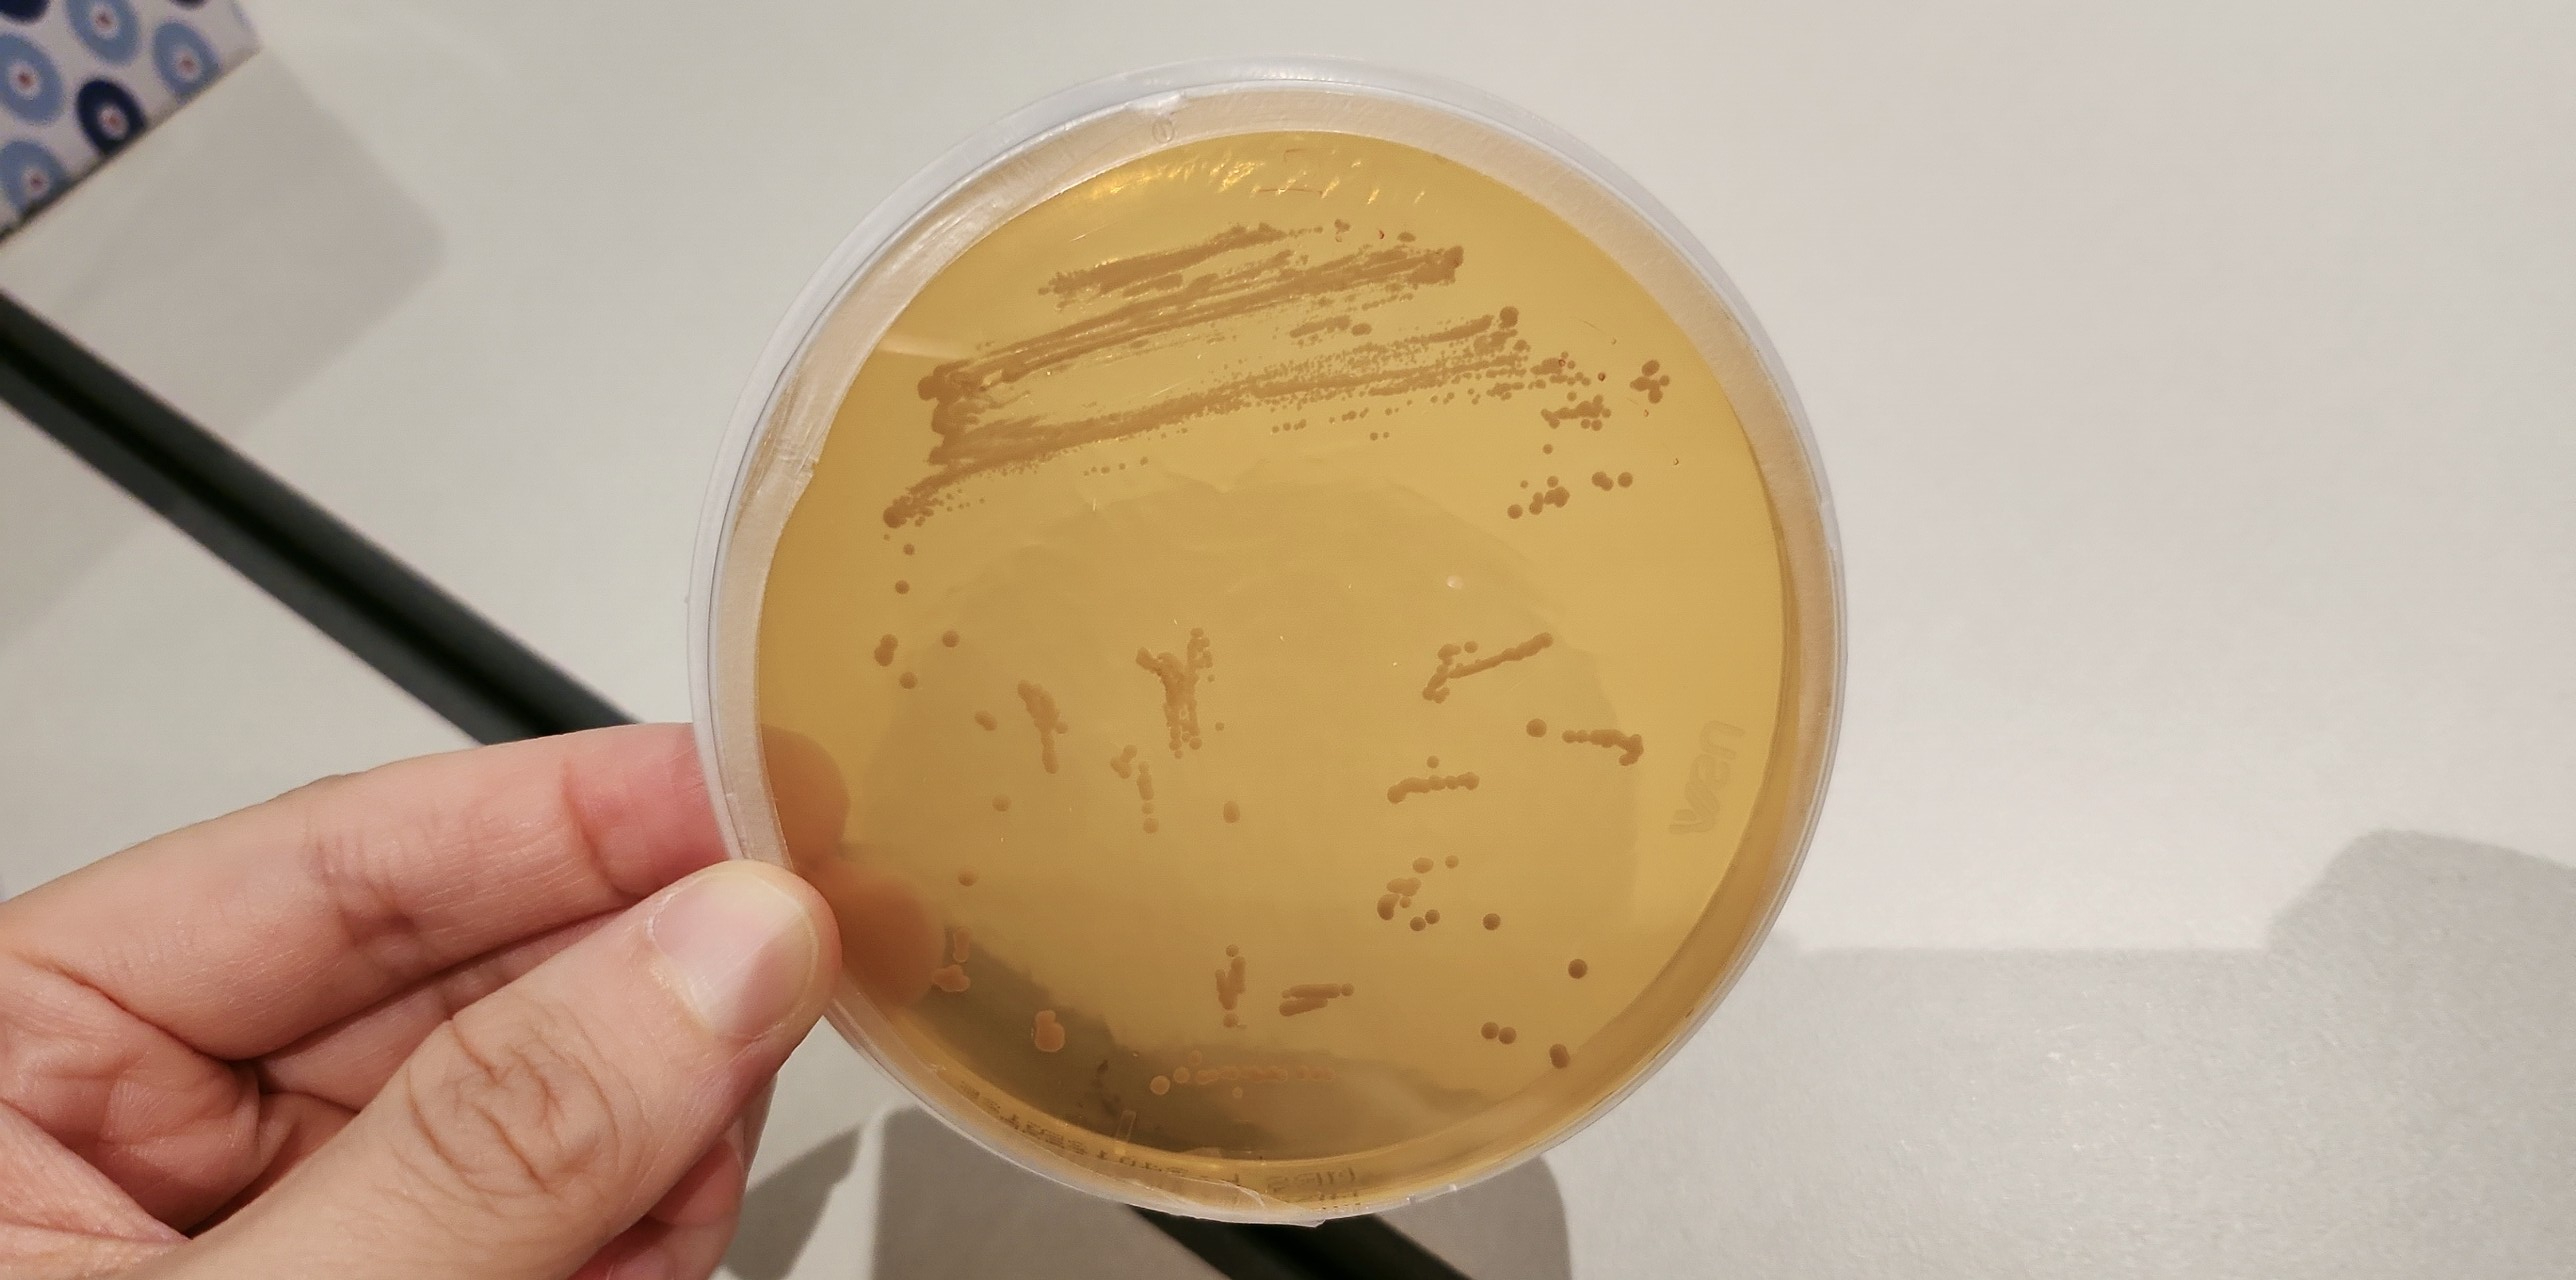
배양 중인 ‘프로바이오틱스 균주’ 샘플 /류빈 기자

65㎖ 야쿠르트도 프로바이오틱스 건기식
hy, 5091종의 자체 균주 라이브러리 보유
장 건강 넘어 신체 전반에 유익한 균주 개발

“K-푸드가 전 세계에 널리 퍼졌듯이 hy는 한국인의, 한국인에 의한, 한국인을 위한 세계 수준의 K-프로바이오틱스를 만들어 한국에서 온 프로바이오틱스는 믿을 만하다는 인식을 세계에 널리 퍼트릴 수 있게 하는 것이 최종 목표다.”
국내 프로바이오틱스 시장에서 매출 1위를 차지하는 hy가 국내 시장을 넘어 전 세계에 ‘K-프로바이오틱스’를 알리기 위한 노력과 개발에 앞장서겠단 포부를 밝혔다.
hy는 지난 20일 오후 서울 중구에 위치한 엠버서더 아카데미에서 미디어 대상 ‘프로바이오틱스 클래스’를 진행했다. 약 1시간 40여 분간 진행된 강의와 실습을 통해 프로바이오틱스에 대한 역사와 개념, 미래에 대해 소개했다.
국내 건강기능식품(건기식) 시장에서 홍삼, 비타민 다음으로 많이 팔리는 것이 바로 프로바이오틱스다. 시장 규모는 약 8900억원 수준으로 추산되며 꾸준한 성장세를 보인다.
프로바이오틱스는 섭취해서 장까지 도달했을 때 장내 환경에 유익한 효과를 내는 균주를 말한다. 체내에 들어가 건강에 좋은 효과를 나타내는 살아있는 균들을 총칭한다고 볼 수 있다. 장에 도달해 장 점막에서 생육할 수 있게 된 프로바이오틱스는 젖산을 생성해 장내 환경을 산성으로 만든다. 산성에 견디지 못하는 유해균을 억제하고 유익균은 증식해 건강한 장 환경을 구축한다.
프로바이오틱스에는 유산균을 포함해 효모균, 박테리아균도 포함된다. 유산균은 탄수화물(당)을 가지고 주변에 유산을 만들어 안 좋은 균을 억제한다. 이에 대부분의 유산균은 프로바이오틱스라고 할 수 있지만 프로바이오틱스가 꼭 유산균이 아닐 수도 있다는 것이다.

유산균의 발견은 와인이 시초
유산균 대부분 프로바이오틱스
65㎖ 야쿠르트도 건기식
한 병에 200억 마리 유산균
우선 유산균의 발견은 와인에서 시작된다. 기원전 8000년 전 고대 조지아에서 와인을 생산하기 시작했으며 와인의 상태, 즉 발효를 통해 유산균을 알게 된 것이다. 이후 1857년 미생물학자인 파스퇴르가 와인의 산패를 연구하면서 와인의 발효는 효모에 의한 발효가 아니라 젖산의 발효이며, 이 발효를 이끄는 세균의 모양이 일반적인 것과 다르다는 것까지 밝혀내게 된다.
이후 1907년 러시아 생물학자 일리야 메치니코프가 노화에 관해 연구하면서 불가리아 지역 노인들의 장수 비결은 유산균이라는 것을 알아냈고 메치니코프 박사가 최초로 발견한 장내 독소를 없애주는 유산균이 ‘락토바실러스 불가리쿠스’다. 이후 1953년 독일의 의사인 베르너 클라트가 건강한 삶의 필수적인 활성 물질을 나타내는 용어로 프로바이오틱스라고 명명했다.
프로바이오틱스의 핵심은 배양이다. 만들어진 배지에 놓여 있는 균을 hy는 한 번 더 중간 배양해 양을 늘린다. 그리고 압축한 것을 스타터라고 부른다. 유산균 스타터를 hy 공장의 큰 대형 탱크에다 넣으면 그 안에서 유산균이 자라게 되고 이렇게 배양한 것에 시럽을 넣으면 야쿠르트, 동결 건조하면 분말 형태의 프로바이오틱스가 된다.
식품의약품안전처 기준 생균으로서 최소한 1g 당 1억 CFU(집락형성단위) 이상 함유해야 건강기능식품이라는 마크를 붙일 수가 있다. 1억 CFU가 모자라는 것은 일반 식품이고 발효유일 수 있다. 2021년까지 국내 식약처는 프로바이오틱스 유형을 가루 형태로만 규정했으나 이후 액상 프로바이오틱스도 인정받게 되면서 65㎖짜리 야쿠르트도 건강기능식품으로 표기할 수 있게 됐다. hy가 1971년 국내 최초로 개발한 액상 발효유 야쿠르트는 한 병(65㎖)에 200억 마리의 유산균이 담겨있다.
hy 관계자는 “프로바이오틱스는 꾸준히 먹어주는 게 좋다. 프로바이오틱스는 2주가 지나면 대변에서 검출되지 않는다”며 “꾸준하게 매일매일 섭취해 장내 유익균의 비중을 맞춰주는 습관을 들이는 게 좋다”고 말했다.
hy, 자체 균주 라이브러리 갖춰
5091종의 국내 최다 균주 보유
신체 전반에 유익한 균주 개발
hy는 자체 균주 라이브러리를 갖고 있고 현재 국내에서 가장 많은 5091종의 균주를 갖고 있다. hy는 새로운 균주를 찾기 위한 프로젝트로 전통시장을 찾아 김치, 탁주, 젓갈 등에서 추출하여 현재의 라이브러리 규모를 갖추게 됐다고 설명했다. hy는 제품 개발 시 원하는 기능성이나 어떠한 특성에 따른 균을 선별할 때 라이브러리에서 골라 연구를 통해 사용하고 있으며, 연간 9억 개의 프로바이오틱스를 생산하고 있다.
김주연 hy 중앙연구소 신소재개발팀장은 “직접 개발한 자체 국내 균주를 사용해 제품을 만들고 소비자 집 앞까지 유통하는 회사는 hy만이 유일하다”고 강조했다.

김 팀장은 “hy는 프로바이오틱스가 장까지 얼마나 살아서 도달할 수 있느냐를 테스트하기 위해 소화관 모사 시스템을 갖추고 있다”면서 “hy는 자체 개발한 장기 배양 공법을 통해 프로바이오틱스가 장까지 살아서 갈 수 있는 특성을 높였다. hy가 개발한 자체 균주 중 하나는 1일 배양했을 때 표준균주하고 장까지 도달해서 사는 비율은 크게 차이가 없는데 7일 배양을 하게 되면 장까지 살아가는 비율이 일반 균주에 비해서 월등히 높다. 이는 우리만의 유일한 기술력과 유일한 균주라고 할 수 있다”고 말했다.
hy는 장 건강 이외에도 두피 모발, 피부 보습, 체지방 감소, 간, 눈, 면역, 여성 건강, 호흡기, 스트레스 감소 등 다양한 신체 기능별 프로바이오틱스 개발을 진행하고 있다. 프로바이오틱스의 먹이가 되는 프리바이오틱스와 관련해서도 지금까지 알려진 다당류 이외에 프리바이오틱스처럼 작용하는 새로운 성분을 발견하기 위한 천연물도 발굴하고 있다. 또한 프로바이오틱스를 이용해 녹용, 홍삼 등 천연물의 기능을 발효를 통해 더 증가시킬 수 있는 연구도 진행하고 있다.
김 팀장은 “hy는 프로바이오틱스 매출과 연간 생산량에서 모두 1위를 차지하고 있다”며 “장 이외에도 신체 전반을 이롭게 하는 프로바이오틱스를 발굴하기 위해 끊임없이 노력하고 있다”고 말했다.
그는 “사실 프로바이오틱스 연구는 어렵다. 라면이나 스낵 같은 가공식품은 신제품을 개발하는데 1년 정도의 기간이 걸리지만 프로바이오틱스는 살아있는 생물이고 이를 발굴하고 안정성과 기능성을 평가하고 제품까지 만들어내는 데 5~6년, 길게는 10년까지도 걸린다”며 “그럼에도 세계 수준의 K-프로바이오틱스를 생산하기 위한 노력을 꾸준히 이어 나가고 있다”고 강조했다.
관련기사
- "내수 성장 한계 돌파"···해외 생산 공장 확보 나선 식품업계
- 아워홈家 장녀 부부 경영 체제 돌입···매각 움직임에 내홍 격화되나
- "잘파세대 입맛 잡아라"···'마라맛'에 빠진 식품업계
- "음향 특화부터 롤플레잉 체험까지"···체험형 극장으로 변모하는 영화관
- "대형마트도 하는데 왜 우리만" 반박 나선 쿠팡···공정위 제재는 지속
- [현장] "K-주얼리 활성화, 법제도 개선 선행돼야"···'종로주얼리포럼 2024' 개최
- "PB 랭킹순 조작·직원 동원 후기" 쿠팡, 과징금 1400억원···"즉각 항소"
- 손 맞잡은 범 삼성가 CJ-신세계, '쿠팡·알리·테무' 이커머스 견제
- "롯데 잠실점 따라올라"···백화점 매출 '1등 굳히기' 나선 신세계
- 외식 물가 상승률, 3년 연속 소비자물가 웃돌아···2분기도 식품 물가 고공행진
- [르포] "K-패션·뷰티 찾는 외국인 관광객"···명동 상권의 화려한 부활
- 美 조선소 인수해 80조 잠수함·군함 시장 정조준하는 한화오션
- '쉬인'까지 한국 진출···'초저가' C-커머스 공세, 패션 시장도 뒤흔드나
- "임영웅 vs 임시완"···폭염 앞두고 생수시장 점유율 각축전 치열
- 트럼프가 K-푸드까지 관세 매길라···식품업계 비상 국면 돌입

